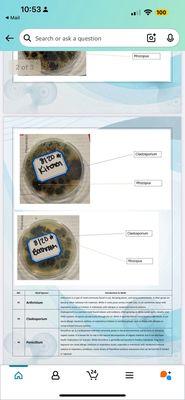
The Villages at McCullers Walk Apartments

This is a great place to call home. I have enjoyed living here. The office associates and Managers are very professional and prompt at addressing any concerns that you may have. The...
Exchange at Holly Springs Apartments
Closed
(4)
Photos
1101 Club Exchange Dr
Holly Springs, NC 27540
Exchange at Holly Springs offers a lifestyle that's moving in the same direction as you. Open, connected and smart. Simplify your every day by living the way you want without compromise - gourmet kitchens and garden tubs to fitness center and bark park. There's room for everything and everyone in your life at Exchange at Holly Springs. Our smart and inviting floor plans are designed to fit anyone's needs! We've paid special attention to the details that add convenience, like electric charging stations and outdoor equipment rentals. Picture yourself entertaining, playing or working in the place that makes it easy. Find the home you've been looking for in Holly Springs and exchange ordinary living for an extraordinary way of life.
Also at this address
Reviews
Betsy W.
6/8/2025
Georgia A.
3/6/2023
I have had a series of unfortunate events to write about and have no clue where to start, so I'll just start here...... it's nightmare on M street. RUN Thank you.
Kate S.
4/29/2021
My husband and I just moved in here one month ago and I have to say, it was one of the best, easiest experiences. We've also been incredibly happy with the building over all - can't hear our...
Jacqueline B.
5/7/2020
This apartment complex is new and beautiful, not to mention the wonderful new additions coming to the area. The customer service I experienced during my search was impeccable from the beginning....
Owner verified
See a problem?
You might also like
Partial Data by Infogroup (c) 2025. All rights reserved.
Partial Data by Foursquare.